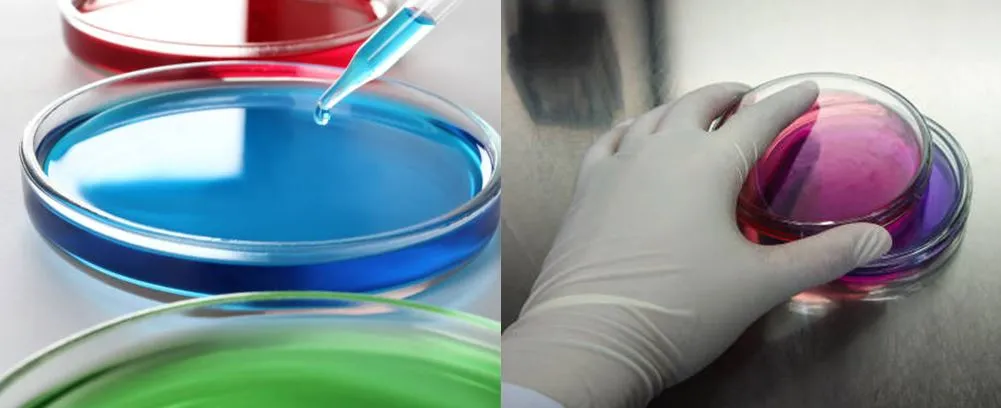
Laboratory glass petri dish 100mm applications Laboratory glass petri dish 100mm applications

Placa de Petri de Vidro de Laboratório 100mm
Uma placa de petri, conhecida como placa de petri ou placa de cultura celular, é um labware para células e cultura microbiana de labware que é feito de uma tampa e um fundo de forma plana redonda ou quadrada. Geralmente, uma placa de petri é feita de vidro borossilicato alto e plástico.
Descrição
Placa de petri de vidro de 100mm de vidro borossilicato alto
Uma placa de petri, conhecida como placa de petri ou placa de cultura celular, é um labware para células e cultura microbiana de labware que é feito de uma tampa e um fundo de forma plana redonda ou quadrada. Geralmente, uma placa de petri é feita de vidro borossilicato alto e plástico. É um dos itens mais comuns em laboratórios de biologia.
Jiangsu Guide Medlab produz muitos tamanhos de placas de petri de vidro de borossilicato alto com base nos padrões da ISO. LOGOTIPO personalizado, tamanhos e pacote são aceitáveis. As placas de petri são embaladas em caixas onduladas de acordo com GB/T 6543; as placas de petri são feitas de vidro 3.3 borossilicato de acordo com os requisitos HG/T 3115.
Especificação do produto
Nome do produto | Placa de petri de vidro de 100mm |
Diâmetro da tampa | ≈103mm |
Diâmetro do fundo | 100mm |
Altura da tampa | 18±2mm |
Altura do fundo | 20±1,5 mm |
Espessura | 1,2 ~2mm |
Resistência à água | HGB2 |
Coeficiente de expansão de fios quentes (20°C ~300°C) | ≤7.5x10-6K-1 |
Temperatura do choque térmico | ≥110°C |
● Diferença de altura da parede do prato
As especificações acima de 90 mm não devem ser maiores que 1,3 mm.
●Avião de placa de Petri
A superfície externa não deve ser convexa. O achatamento da superfície interna deve ser ≤1,5
●Requisitos de defeito de aparência da placa de Petri
Bolhas finas da pele, pequenas bolhas densas, listras desordenadas, listras em espiral, rachaduras de jateamento e outros defeitos óbvios não podem existir.
● Requisitos correspondentes de fundo e tampa da placa de petri
Depois que o fundo da placa de petri e a tampa são instalados, a borda da tampa não é inferior a 2mm do plano externo do fundo da placa.
Aplicação
A placa de petri de vidro pode ser usada em laboratórios, bem como no ensino. As placas de petri são amplamente utilizadas na biologia para cultivar bactérias, moldes e outros; também pode ser usado em química, agricultura, entomologia e outros.

Controle de Qualidade

Embalagem, Armazenamento e Transporte
●Pacote
As placas de petri de vidro de 100mm estão embaladas em uma caixa segura que pode conter 120 peças de 100mm de petri de vidro; no tamanho 49x36x25cm; no peso N.W. 12kg, G.W. 14kg. Os produtos devem ser embalados em caixas onduladas de acordo com GB/T 6543; Um espaçador deve ser colocado entre o fundo e a tampa da placa de petri; A embalagem externa deve estar em conformidade com as disposições pertinentes de GB/T 191;A embalagem externa mostrará nome do produto, especificação e quantidade, peso líquido, peso bruto e volume e outros.
●Armazenamento
Os produtos devem ser armazenados dentro de casa após a embalagem, a altura do empilhamento não deve exceder 10 camadas, não deve estar em contato com ácido forte, álcali forte, cloreto e outras substâncias químicas.
●Transporte
Este produto pode ser transportado por qualquer meio de transporte, carga e descarga não deve ser lançado.

PERGUNTAS FREQÜENTES
1.Quantos tipos de placa de petri?
Podemos fornecer pratos de plástico e vidro petri em vários tamanhos.
2.Você pode fornecer serviço personalizado?
Certo. Podemos fornecer logotipo personalizado, pacote e outros.
3.Por que escolher você?
Boa experiência em laboratórios. Temos equipe técnica de profissão e equipe de vendas. Garantimos a qualidade dos produtos; atendemos a todos os clientes; fazemos mais promessas relacionadas à garantia de qualidade e operação.
Tag: petri placa de vidro de laboratório 100mm, China, fornecedores, fabricantes, fábrica, personalizado, atacado, preço, lista de preços, amostra gratuita













